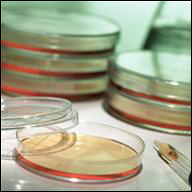
infectious disease

| July 1, 2015 · Volume 14, Issue 15 |
|
|
OSHA fines Texas DuPont plant more than $270K during second inspection after four workers die from chemical exposure
Four workers at a DuPont chemical facility in La Porte, Texas, were fatally asphyxiated in November 2014 when a supply line unexpectedly released more than 20,000 lbs. of methyl mercaptan, a deadly chemical. After the initial investigation into the deaths, OSHA found hazards that prompted the inspection to be expanded under the National Emphasis Program for Chemical Facilities. OSHA issued citations to DuPont for three willful, one repeat and four serious violations, with proposed penalties of $273,000 for these new violations. "DuPont promotes itself as having a 'world-class safety' culture and even markets its safety expertise to other employers, but these four preventable workplace deaths and the very serious hazards we uncovered at this facility are evidence of a failed safety program," said Assistant Secretary of Labor for Occupational Safety and Health Dr. David Michaels. "Nothing can bring these workers back to their loved ones. I hope that our continued scrutiny into this facility and into working conditions at other DuPont plants will mean no family ever suffers this loss again." OSHA has also placed the company in its Severe Violator Enforcement Program. For more information, see the news release. Texas manufacturer with long history of violations fined more than $321K after repeatedly allowing workers to operate defective press After an inspection prompted by a formal complaint, OSHA identified 13 safety and health citations at D&D Manufacturing Inc., a metal stamping plant in El Paso, Texas, with a 15-year history of safety violations. The company was cited for exposing workers to amputations and other serious injuries from unsafe machinery, including a violation for ignoring the danger of allowing employees to work with a defective 500-pound metal press that the company knew had repeatedly dropped without warning. Completed under OSHA's National Emphasis Program on Amputations, the inspection resulted in $321,750 in proposed department fines for D&D. This inspection follows one in December 2014 that resulted in 36 federal citations for serious safety violations. "D&D is aware of the dangers at its production facility, but has done nothing to correct them. An employee could have been seriously injured," said Diego Alvarado Jr., OSHA's area director in El Paso. For more information, see the news release. New Jersey furniture company and staffing agency fined more than $196K for repeatedly exposing workers to hazards
OSHA issued 42 safety and health citations against Sterling Seating Inc. after an inspection found that the North Arlington, N.J., furniture manufacturer exposed workers to amputation, electrical and exit route hazards, and failed to train employees on the effects of hazardous chemicals. Sterling Seating was fined $176,330. On Target Staffing LLC in Newark, N.J., which provided the workers to Sterling, was also cited and fined $19,800 for not having a written hazard communication program or training. "Host employers and staffing agencies share a responsibility for worker safety," said Lisa Levy, area director of OSHA's Hasbrouck Heights Area Office. "Those that fail to ensure that safety will be held legally responsible." For more information, read the news release. Florida construction company managers held in contempt of court; ordered to pay more than $195K in penalties
Guillermo Perez and Elma Maldonado, president and vice president of Florida-based GP Roofing & Construction LLC, were arrested in June for failing to comply with a civil contempt order. OSHA conducted nine inspections in 2011 and 2012 of GP Roofing worksites in Florida that resulted in multiple violations of OSHA fall protection, eye and face protection, safe ladder, and other standards. GP Roofing and its officers were held in civil contempt after the company continued to violate OSHA standards and failed to pay penalties. The company was ordered to pay outstanding penalties of $195,170 plus interest and fees, and certify that it had corrected the violations. "This enforcement action demonstrates that OSHA can and will take action to ensure that standards are followed and that companies like GP Roofing that ignore multiple court orders requiring correction of violations and payment of penalties will be held accountable," said Kurt Petermeyer, regional administrator for OSHA in Atlanta. Read the news release for more information. Please visit the enforcement news releases page for more on OSHA enforcement activity.
Brooklyn hospital settlement aims to protect healthcare workers from violence on the job
Following the 2014 assault of a nurse by a patient, Brookdale University Hospital and Medical Center has entered into a settlement agreement with OSHA to implement a program that will better safeguard its employees against workplace violence. The agreement calls for administrative controls including employee training; more comprehensive violence prevention; improved communication with employees; guidance for actions before, during and after workplace violence incidents; and consultation with an expert on workplace violence in hospital settings. "Healthcare and social service workers face job-related violence risks, but effective, proactive employer policies can curtail these dangers," said Robert Kulick, OSHA's regional administrator in New York. "This agreement and its comprehensive corrective measures are great examples of what healthcare facilities should do to protect their employees better." In August 2014, OSHA cited the Brooklyn, N.Y., medical facility for failing to properly protect its workers against on-the-job violence. For more information on the settlement agreement, read the news release. To learn more about workplace violence prevention, visit OSHA's Safety and Health Topics page on workplace violence. OSHA decision upheld in the 2012 fatal stabbing of healthcare worker by client with a history of violent behavior
In June, the Occupational Safety and Health Review Commission affirmed that a Florida healthcare service company failed to protect their worker from violence in the workplace which ultimately led to the worker’s death. A healthcare coordinator with Integra Health Management was fatally stabbed by a client in 2012. The firm was aware of the client's violent criminal history but failed to develop and implement safety practices to protect their employee. In 2013, OSHA cited Integra Health Management and proposed $10,500 in fines for failing to protect their employees from workplace violence and report the health care coordinator's death to OSHA. Leslie Grove, director of the OSHA Tampa Area Office stated "Employers must take every reasonable precaution to protect employees against safety and health hazards in the workplace, including physical assaults." On June 25, OSHA added workplace violence along with musculoskeletal disorders, bloodborne pathogens, tuberculosis, and slips, trips and falls as key hazards that will be focused on in future OSHA investigations in the health care industry. For more information, see the news release. Alabama social services center failed to protect employees from being injured by violent clients
OSHA inspected a therapeutic treatment center run by Gateway, a social services organization in Birmingham, Ala., in response to a complaint alleging workplace violence. OSHA issued one general duty clause citation after finding that the employer failed to protect workers from the hazards of physical assault while providing care for adolescent children and teenagers known to exhibit violent behavior tendencies. Workers suffered injuries such as, bites, abrasions, contusions and stab wounds. "During our investigation, it became clear that management was well aware that its employees were being injured by violent clients for several years, yet they took no action to protect their workers," said Ramona Morris, OSHA's director of the Birmingham Area Office. Proposed penalties are $7,000. For more information, see the news release. OSHA directive updates inspection procedures for protecting workers from tuberculosis in healthcare settings
OSHA has updated instructions for conducting inspections and issuing citations related to worker exposures to tuberculosis in healthcare settings. According to the CDC, nearly one-third of the world's population is infected with TB, which kills almost 1.5 million people per year. In 2013, more than 9,500 TB cases were reported in the United States, and nearly 400 of those cases were among healthcare workers. OSHA's updated instructions incorporate guidance from the Centers for Disease Control and Prevention. The revised directive does not create any additional enforcement burdens for employers; it simply updates OSHA's inspection procedures with the most currently available public health guidance. This directive also covers additional workplaces regarded as healthcare settings, such as sites where emergency medical services are provided and laboratories handling clinical specimens that may contain TB. For more information see the news release or visit OSHA’s Tuberculosis Safety and Health Topics page.
OSHA issues temporary enforcement policy for confined spaces in construction
OSHA is instituting a 60-day temporary enforcement policy of its Confined Spaces in Construction standard. Full enforcement of the new standard, which goes into effect Aug. 3, is being postponed to Oct. 2 in response to requests for additional time to train and acquire the equipment necessary to comply with the new standard. During this 60-day temporary enforcement period, OSHA will not issue citations to employers who make good faith efforts to comply with the new standard. Employers must be in compliance with either the training requirements of the new standard or the previous standard. Employers who fail to train their employees consistent with either of these two standards will be cited. Factors that indicate employers are making good faith efforts to comply include: scheduling training for employees as required by the new standard; ordering the equipment necessary to comply with the new standard; and taking alternative measures to educate and protect employees from confined space hazards. OSHA issued the Confined Spaces in Construction final rule on May 4, 2015. OSHA estimates that the rule could protect nearly 800 construction workers a year from serious injuries and reduce life-threatening hazards. For more information, read the news release.
OSHA to hold meeting of the Federal Advisory Council on Occupational Safety and Health OSHA will hold a meeting of the Federal Advisory Council on Occupational Safety and Health July 16 in Washington, D.C. The tentative agenda includes updates from FACOSH subcommittees and discussions of OSHA’s Voluntary Protection Program, practices for protecting federal workers from retaliation, and the Presidential POWER Initiative. The committee will meet from 1 – 4:30 p.m., Thursday, July 16 in Rooms N-4437 A-D, U.S. Department of Labor, 200 Constitution Ave., N.W., Washington, DC 20210. The meeting is open to the public. FACOSH advises the Secretary of Labor on all matters relating to the occupational safety and health of federal employees. This includes providing advice on how to reduce the number of injuries and illnesses in the federal workforce and how to encourage each federal executive branch department and agency to establish and maintain effective occupational safety and health programs. Florida meeting of the Maritime Advisory Committee for Occupational Safety and Health scheduled for Sept. 1-2
OSHA has scheduled a meeting of the Maritime Advisory Committee for Occupational Safety and Health for Sept. 1-2, in Tampa, Fla. The Longshoring and Shipyard Work Groups will meet Sept. 1 and the full committee will meet Sept. 2. The meeting agenda items include a presentation on OSHA 10 and 30-hour Maritime Outreach Training and an OSHA field report on maritime activities. The full committee will also hear reports from the Longshoring and Shipyard workgroups, which will discuss topics including Shipyard Competent Person programs; fire and rescue services in shipyards; mechanic safety in longshoring operations; and translating OSHA maritime guidance documents into Spanish. Individuals may electronically submit comments or requests to speak through www.regulations.gov, the Federal eRulemaking Portal. Comments and requests can also be submitted by mail or facsimile. The deadline for submissions is Aug. 10. For more details, including the meeting location, see the Federal Register notice.
Training event to enhance federal worker safety and health to be held July 28-30 A three-day training event for federal agency staff responsible for workplace safety and health issues will be held July 28-30 in Arlington Heights, Ill. The OSHA Training Institute, in collaboration with OSHA's Office of Federal Agency Programs, will conduct a series of half-day seminars that discuss safety- and health-related topics such as hearing conservation, asbestos management and housekeeping, construction safety, industrial hygiene sampling methods, and forklift and material handling. OSHA developed this training event to ensure that federal agencies and their health and safety personnel know how to provide safe and healthful workplaces for federal employees. Registration will remain open until July 22. Students can access registration forms, course descriptions, and other details on OSHA's website.
Illinois metal processor earns SHARP recognition through OSHA's On-site Consultation Program
Becker Iron and Metal Inc., in Venice, Ill., is one of the leading scrap metal recyclers in the Midwest and beyond. In 2011, the company contacted OSHA’s On-site Consultation Program, which offers free and confidential occupational safety and health advice to small and medium-sized businesses across the country, with priority given to high-hazard worksites. The services are separate from enforcement and do not result in penalties or citations. Hazards identified during the first on-site consultation visit included worker exposure to metal fumes, damaged electrical cords and unsafe machinery. To eliminate amputation and electrical hazards, Becker eliminated or replaced dangerous equipment and implemented a new lockout/tagout program with subsequent employee training. The company also purchased new scrap cutting equipment to reduce worker exposures to metal fumes and implemented comprehensive respiratory protection and hearing conservation programs. Becker's dedication to protecting workers was rewarded in 2014 when the company was accepted into OSHA's Safety and Health Achievement Recognition Program. Acceptance of a company into SHARP is an achievement of status that singles out the company among its business peers as a model for worksite safety and health. For more information, see Becker Iron and Metal Inc.'s success story.
Protecting workers from heat illness and falls
Virginia announces new worker misclassification policy
On June 2, 2015, the Virginia Department of Labor and Industry announced a new Virginia Occupational Safety and Health policy for preventing the misclassification of workers in Virginia. At the heart of the matter is improper classification of workers as independent contractors. Virginia put its revised policy in place to both improve protections, including occupational safety and health protections, for these workers while simultaneously seeking to level the playing field for employers who are classifying their workers correctly. VOSH implemented specific policy changes effective July 1, 2015 for employers found to be misclassifying workers, which include:
Additional information, including a copy of the policy memorandum and news release, is available on the VOSH website.
New young workers' rights video now available in Spanish OSHA wants every young worker to be safe on the job. That's why the agency has released a new video promoting the rights of young workers. The video emphasizes all young workers' rights to a safe and healthful workplace as well as fair wages. It is available in both English and Spanish and will be shared through the Department of Labor's social media feeds, including Twitter @USDOL and @USDOL_Latino and Facebook. New video highlights heat illness prevention
As temperatures rise across the country this summer, outdoor workers may find themselves at risk of serious heat illness. But workers can stay safe and healthy if employers remember three simple words: Water, Rest, and Shade. These are the pillars of OSHA's Campaign to Prevent Heat Illness in Outdoor Workers, now in its fourth year. OSHA's new video reminds employers and workers of the importance of acclimatization, recognizing common symptoms, and following best practices to prevent heat illness. The video is also available in Spanish to reach Latinos who may be working in extreme heat this summer. Visit the campaign page in English or Spanish for more information, resources, and tools for training your workforce.
Follow us on Twitter and visit us on Facebook Thanks for following and retweeting! Continue following @USDOL on Twitter and visiting the DOL Facebook page for up-to-the-minute OSHA information and resources. OSHA provides news and commentary on workplace safety and health from its senior leadership, staff and guest contributors on the DOL blog. See our latest posts:
Are you interested in a career with the Department of Labor? DOL has job opportunities throughout the country, including openings in OSHA.
See DOL's weekly electronic newsletter for more DOL news. For more frequent updates on OSHA activities follow DOL on QuickTakes is emailed free twice monthly to nearly 71,000 subscribers. You can receive it faster and easier by subscribing to the QuickTakes is a product of OSHA's Office of Communications. If you have comments or suggestions that you think could improve the quality of QuickTakes, please submit them to OSHA.QuickTakes@dol.gov or contact the Office of Communications at 202-693-1999. [Note: This address is for input on QuickTakes only. Other questions concerning OSHA should be submitted through the agency's Electronic Mail Form.] For more information on occupational safety and health, visit OSHA's website. If this email was forwarded to you and you'd like to subscribe, please visit: https://www.osha.gov/as/opa/quicktakes/subscribe.html. Register for your FREE QuickTakes newsletter today! You may also remove yourself from the OSHA QuickTakes Subscription list at the above webpage. Thank you. |